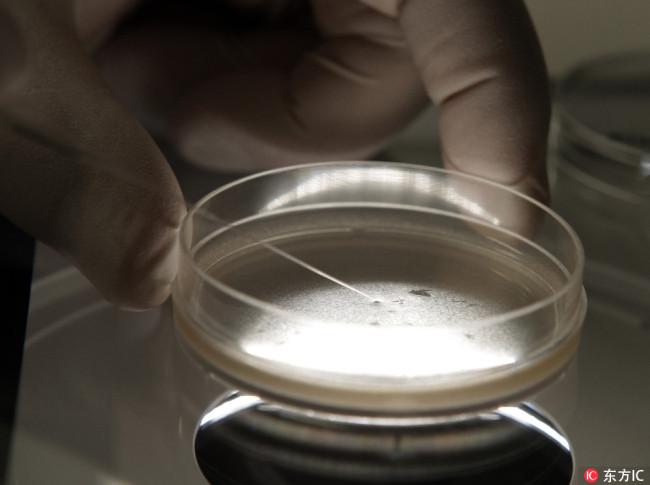

Beijing, 23 nov (Xinhua) -- Um padr?o geral para as pesquisas em tecnologia de células-tronco foi publicado na China na quarta-feira.
O documento introduz requisitos gerais sobre triagem de doadores, coleta do tecido, separa??o e preserva??o celular, transporte e detec??o de células-tronco.
Os requisitos gerais v?o proteger os interesses dos doadores e promover o desenvolvimento padronizado do setor, de acordo com Zhou Qi, chefe do bra?o de células-tronco da Sociedade Chinesa de Biologia Celular, que liderou a compila??o do padr?o.
O padr?o contribuirá para as pesquisas em rela??o à diferencia??o de células-tronco, disse Zhou, acrescentando que um padr?o nacional mais detalhado será publicado mais tarde.
Conta oficial de Wechat da vers?o em português do Diário do Povo Online